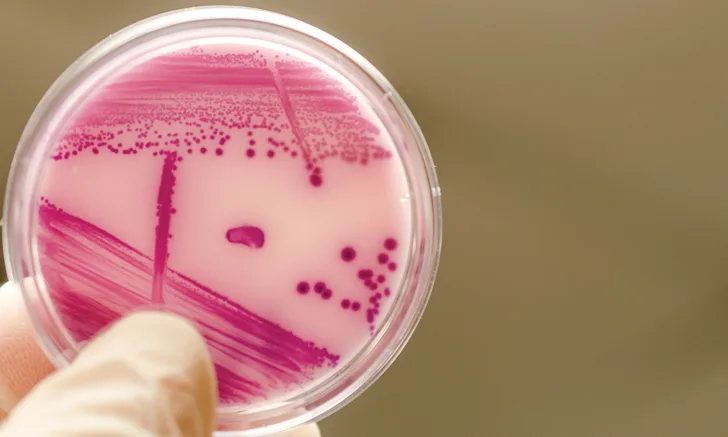

Interpretation of Culture & Susceptibility Reports
Patricia M. Dowling, DVM, MS, DACVIM (Large Animal), DACVCP, Western College of Veterinary Medicine, Saskatoon, Saskatchewan, Canada
Antimicrobial stewardship programs typically recommend culture and susceptibility testing to guide clinicians in choosing optimal antimicrobial therapy; however, the majority of antimicrobial selections are made empirically,1,2 rather than based on test results from individual patients. Antimicrobial selection guided by culture and susceptibility testing is conducted mostly for chronic or recurrent infections.3,4
Culture and susceptibility reports are often underused by veterinary practitioners because of a number of limitations, including cost and the time delay between sampling and results.4 Even after results are obtained, clinicians may lack the information necessary to interpret the reports in a meaningful way.
Culture & Susceptibility Reports
A culture and susceptibility report from a microbiology laboratory identifies the bacterial pathogen and lists antimicrobials labeled with an S, R, or I, designating Susceptible, Resistant, or Intermediate, respectively.5 These labels indicate the likelihood of a clinical response to antimicrobial treatment. Categories are determined by clinical breakpoints (ie, values that express whether specific bacterial pathogens will respond to certain antimicrobials), which are determined for specific antimicrobial/bacteria combinations based on the minimum inhibitory concentration (MIC) and the designation S, R, or I that corresponds to a specific MIC value (see Determining Breakpoints). MIC values are based on populations of the specific bacteria, the pharmacodynamic data for a specific species, and evidence from clinical use in patients treated with that antimicrobial.6 The clinical use is specific to the dose regimen (ie, dose, route of administration, frequency of administration) and disease. If any aspect of the regimen is altered (eg, the drug is administered orally instead of by injection), the predictive values of the breakpoints are no longer reliable.
Determining Breakpoints5-6
Breakpoint: The specific concentration of an antimicrobial that defines susceptibility or resistance
MIC: The lowest concentration of an antimicrobial required to inhibit the growth of specific bacteria
MIC less than local drug concentration: Associated with a high likelihood of therapeutic success, therefore susceptible (S)
MIC equal to local drug concentration: Associated with an uncertain effect; might be effective if concentrated at the site of infection or if the dose is increased, therefore intermediate (I)
MIC greater than local drug concentration: Associated with a high likelihood of therapeutic failure, therefore resistant (R)
Established Breakpoints
The Clinical Laboratory Standards Institute (CLSI) sets the standards for conducting and interpreting veterinary antimicrobial susceptibility tests.7 Breakpoints have been set only for a limited number of antimicrobial/bacteria combinations in veterinary species. If veterinary breakpoints are not available, breakpoints derived from human data are often provided on the report; this practice, however, is controversial, with some veterinary microbiologists stating that interpretation from nonveterinary breakpoints should not be performed or should only be performed with extreme caution.8,9 The CLSI recommends that microbiology laboratories should inform clinicians of the breakpoint source (ie, human or veterinary), but such designations rarely appear on culture and susceptibility reports. Thus, the report must be used in conjunction with knowledge of the pharmacokinetics and pharmacodynamics of the antimicrobial and the pathophysiology of the disease to determine if a specific drug is a reasonable treatment option (see Table).10
Diagnostic laboratories independently choose which bacterial isolates and which antimicrobial susceptibilities to report. Although laboratories recommend reporting only isolates that are clinically relevant, as reporting clinically irrelevant isolates can lead to unnecessary antimicrobial use, this would require oversight by a veterinary microbiologist with an adequate clinical background1; however, not all laboratories have the services of such specialists. It is also recommended that laboratories practice selective reporting (ie, all determined susceptibilities are not automatically reported), which helps prevent clinicians from choosing antimicrobials for cases in which they are not appropriate.1 For example, the susceptibility of an Escherichia coli isolate to nitrofurantoin should only be reported for isolates from an uncomplicated UTI, as UTI is the only clinical situation in which nitrofurantoin is an effective treatment. Susceptibilities for last resort drugs important in human medicine (eg, vancomycin, imipenem) should not be routinely reported.
Resistance & Susceptibility
It is important to recognize intrinsic resistance when interpreting culture and susceptibility reports.11 There are certain antimicrobial/bacteria combinations for which resistance should be assumed (eg, enterococci and cephalosporins). Some pathogens are intrinsically resistant to most major categories of antimicrobials. For example, Pseudomonas aeruginosa is a common secondary invader in cases of chronic otitis externa in dogs. Therefore, it is common to see resistance reported to all antimicrobials except aminoglycosides, fluoroquinolones, and antipseudomonal penicillins (eg, piperacillin). As another example, methicillin-resistant staphylococci should be reported as resistant to all penicillins and cephalosporins and imipenem; even if in vitro test results indicate susceptibility, the laboratory should report the result as resistant if there is a known intrinsic resistance. Results reported as susceptible should be questioned, as they are most likely the result of an identification or susceptibility testing error, indicating potential problems with the laboratory’s adherence to standard guidelines.
Unexpected resistance results (eg, penicillin-resistant streptococci) should also be identified and investigated (see Table). Although such results might be due to the emergence of antimicrobial resistance, it is more commonly the result of laboratory error.8,12
Rather than listing drugs in alphabetical order, it is preferable for the reporting laboratory to list drugs in groups according to class and in order of appropriate first-line, second-line, and third-line treatment choices to support prudent antimicrobial use. Cross-resistance often occurs within classes of antimicrobials and may be more difficult for the clinician to visualize if drugs are listed in alphabetical order. This order may also prevent practitioners from simply choosing the first drug labeled “S” for therapy.
Breakpoint Sources for & Resistance to Common Antimicrobials
This table provides antimicrobials commonly found on small animal culture and susceptibility reports and is organized according to antimicrobial classification and a general preference for order of use. Breakpoint information is derived from CLSI performance standards for veterinary isolates.7
Penicillins
Cephalosporins
Tetracyclines
Sulfonamides
Macrolides/Lincosamides
Phenicols
Fluoroquinolones
Aminoglycosides
Limited-Use Antimicrobials
CLSI = Clinical Laboratory Standards Institute, ESBL bacteria = extended-spectrum β-lactamase–producing bacteria, MIC = minimum inhibitory concentration